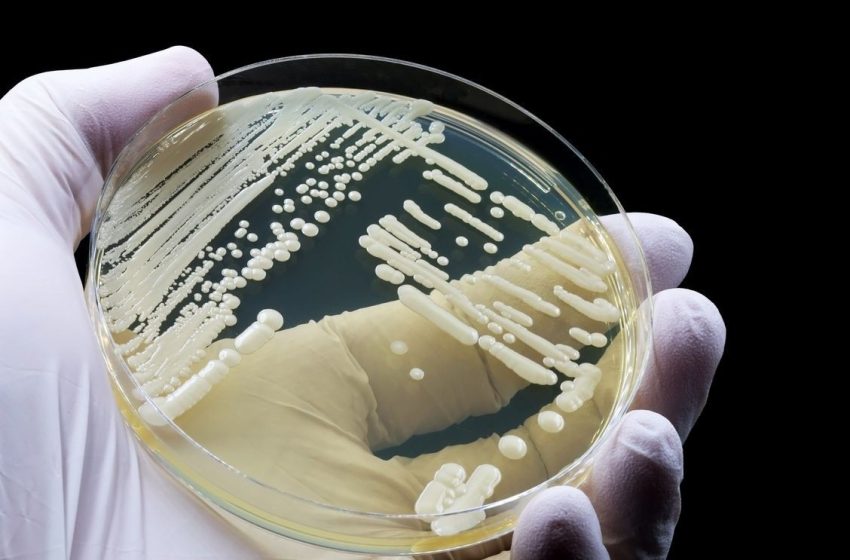
Experts point to cause behind Candida Auris spike in Tennessee

Experts point to cause behind Candida Auris spike in Tennessee
CHATTANOOGA, Tenn. — The Tennessee Department of Health reports that there are eight active screening cases and forty clinical cases of Candida Auris in Tennessee so far this year.
Just a decade ago, the fungus was practically unheard of; there were only 51 known clinical C. auris cases across just four states that year.
Now, the World Health Organization classifies C. auris as one of the most dangerous fungal superbugs.
We spoke with an infectious disease professor at Vanderbilt University Medical Center about the impact across the Tennessee Valley.
FHO C. AURIS CASES SURGING IN TN SEGMENT 3.15.26
“First of all, it’s resistant to a lot of the treatments we have. Number two, it affects people who are older, have complex medical conditions, surgery. Interestingly enough, there’s a lot of Candida Auris internationally, and so some people who’ve gone abroad and been hospitalized for medical care can bring that infection back home with them, said Dr. Schaffner, Professor of Infectious Diseases, Vanderbilt University Medical Center.”
Right now, the Tennessee Department of Health is closely monitoring and surveilling the situation.
Officials are reaching out to help institutions where Candida auris may be spreading, providing infection control guidance to minimize the risk to their patients.
We asked Dr. Schaffner where the infection is most likely to appear.
“Well, those common places are in hospitals and in post-hospitalization, acute care. Facilities where people get transported in order for their care after they’re hospitalized. Remember, these are almost 100% very seriously ill patients, said Dr. Schaffner, Professor of Infectious Diseases, Vanderbilt University Medical Center.”

CDC experts want to reiterate the importance of frequent hand-washing to help prevent the spread.
For more information about c. Aurisis, you can visit here.
First Appeared on
Source link






